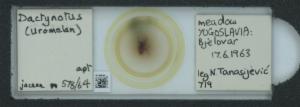

| Data resource | Natural History Museum (London) Collection Specimens |
| Image Identifier | 3ce4d3b5-3fab-43f7-97af-3a57e314615d |
| Occurrence ID(s) | |
| Title | 010098755_112827_1096678 |
| Creator | |
| Created | 2016-03-17T08:33:38Z |
| Description | |
| Publisher | |
| References | |
| Audience | |
| Source | |
| Linear scale | <not calibrated> |
| Date uploaded | 14 Nov, 2024 21:48:03 |
| Uploaded by | <Unknown> |
| Date taken/created | 14 Nov, 2024 21:48:03 |
| Rights | |
| Rights holder | The Trustees of the Natural History Museum, London |
| Licence |

|
| Data resource UID | dr40 |
| Dimensions (w x h) | 1440 x 512 |
| File size | 58.8 KB |
| Mime type | image/jpeg |
| Type | StillImage |
| Image URL | https://images-bioatlas.bioportal.hr/store/d/5/1/6/3ce4d3b5-3fab-43f7-97af-3a57e314615d/original |
| MD5 Hash | 803a92817af88d8273d8f91bad297f34 |
| SHA1 Hash | e5539883708c74666a4a948ac0de0758f79bf953 |
| Size on disk (including all artifacts) | 274.2 KB |